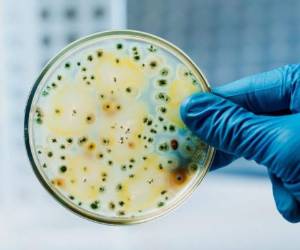

WASHINGTON, ESTADOS UNIDOS.- El Senado de Estados Unidos avanzó la noche del jueves en un proyecto de ley contra la violencia con armas de fuego al aprobar nuevas restricciones a las armas de fuego y destinar miles de millones de dólares en fondos para la salud mental y la seguridad escolar
La ley, que casi con seguridad será ratificada por la Cámara de Representantes el viernes, no satisface las demandas de los opositores a las armas y del presidente Joe Biden, pero es considerada un avance tras casi 30 años de inercia en el Congreso.
LEA TAMBIÉN: Joe Biden propone suspender impuesto sobre la gasolina por 3 meses en EEUU
La ley bipartidista fue respaldada por los 50 senadores demócratas y 15 republicanos, incluye la mejora de la comprobación de los antecedentes de los compradores menores de 21 años, 11,000 millones de dólares de financiación para la salud mental y 2,000 millones de dólares para programas de seguridad escolar.
También destina fondos para incentivar a los estados a aplicar leyes de “alerta” para retirar las armas de fuego a personas consideradas amenazantes.
Y también cierra el llamado agujero del “novio”, por el cual los maltratadores domésticos podían evitar la prohibición de comprar armas de fuego si no estaban casados o no vivían con su víctima.
“El Senado de Estados Unidos está haciendo esta noche algo que muchos creían imposible hasta hace unas semanas: estamos aprobando el primer proyecto de ley de seguridad de armas significativo en casi 30 años”, dijo el líder de la mayoría demócrata del Senado, Chuck Schumer.
“El proyecto de ley de seguridad de las armas que estamos aprobando esta noche puede describirse con tres adjetivos: bipartidario, de sentido común, salvador de vidas”, dijo.
VEA: Cuñada de “El Chapo” Guzmán es vigilada por las autoridades federales de México
El senador republicano Mitch McConnell dijo que la ley tornará a Estados Unidos más seguro “sin hacer menos libre a nuestro país”.
“Este es un paquete (de normas) de sentido común. Sus disposiciones son muy, muy populares. Contiene cero nuevas restricciones, cero nuevos periodos de espera, cero mandatos y cero prohibiciones de ningún tipo para los propietarios de armas respetuosos con la ley.”
La poderosa La Asociación Nacional del Rifle y muchos republicanos de ambas cámaras del Congreso se oponen, pero la iniciativa cuenta con el respaldo de grupos que trabajan en temas policiales, violencia doméstica y enfermedades mentales.
ADEMÁS: Investigan intento de Donald Trump de “corromper” al Departamento de Justicia